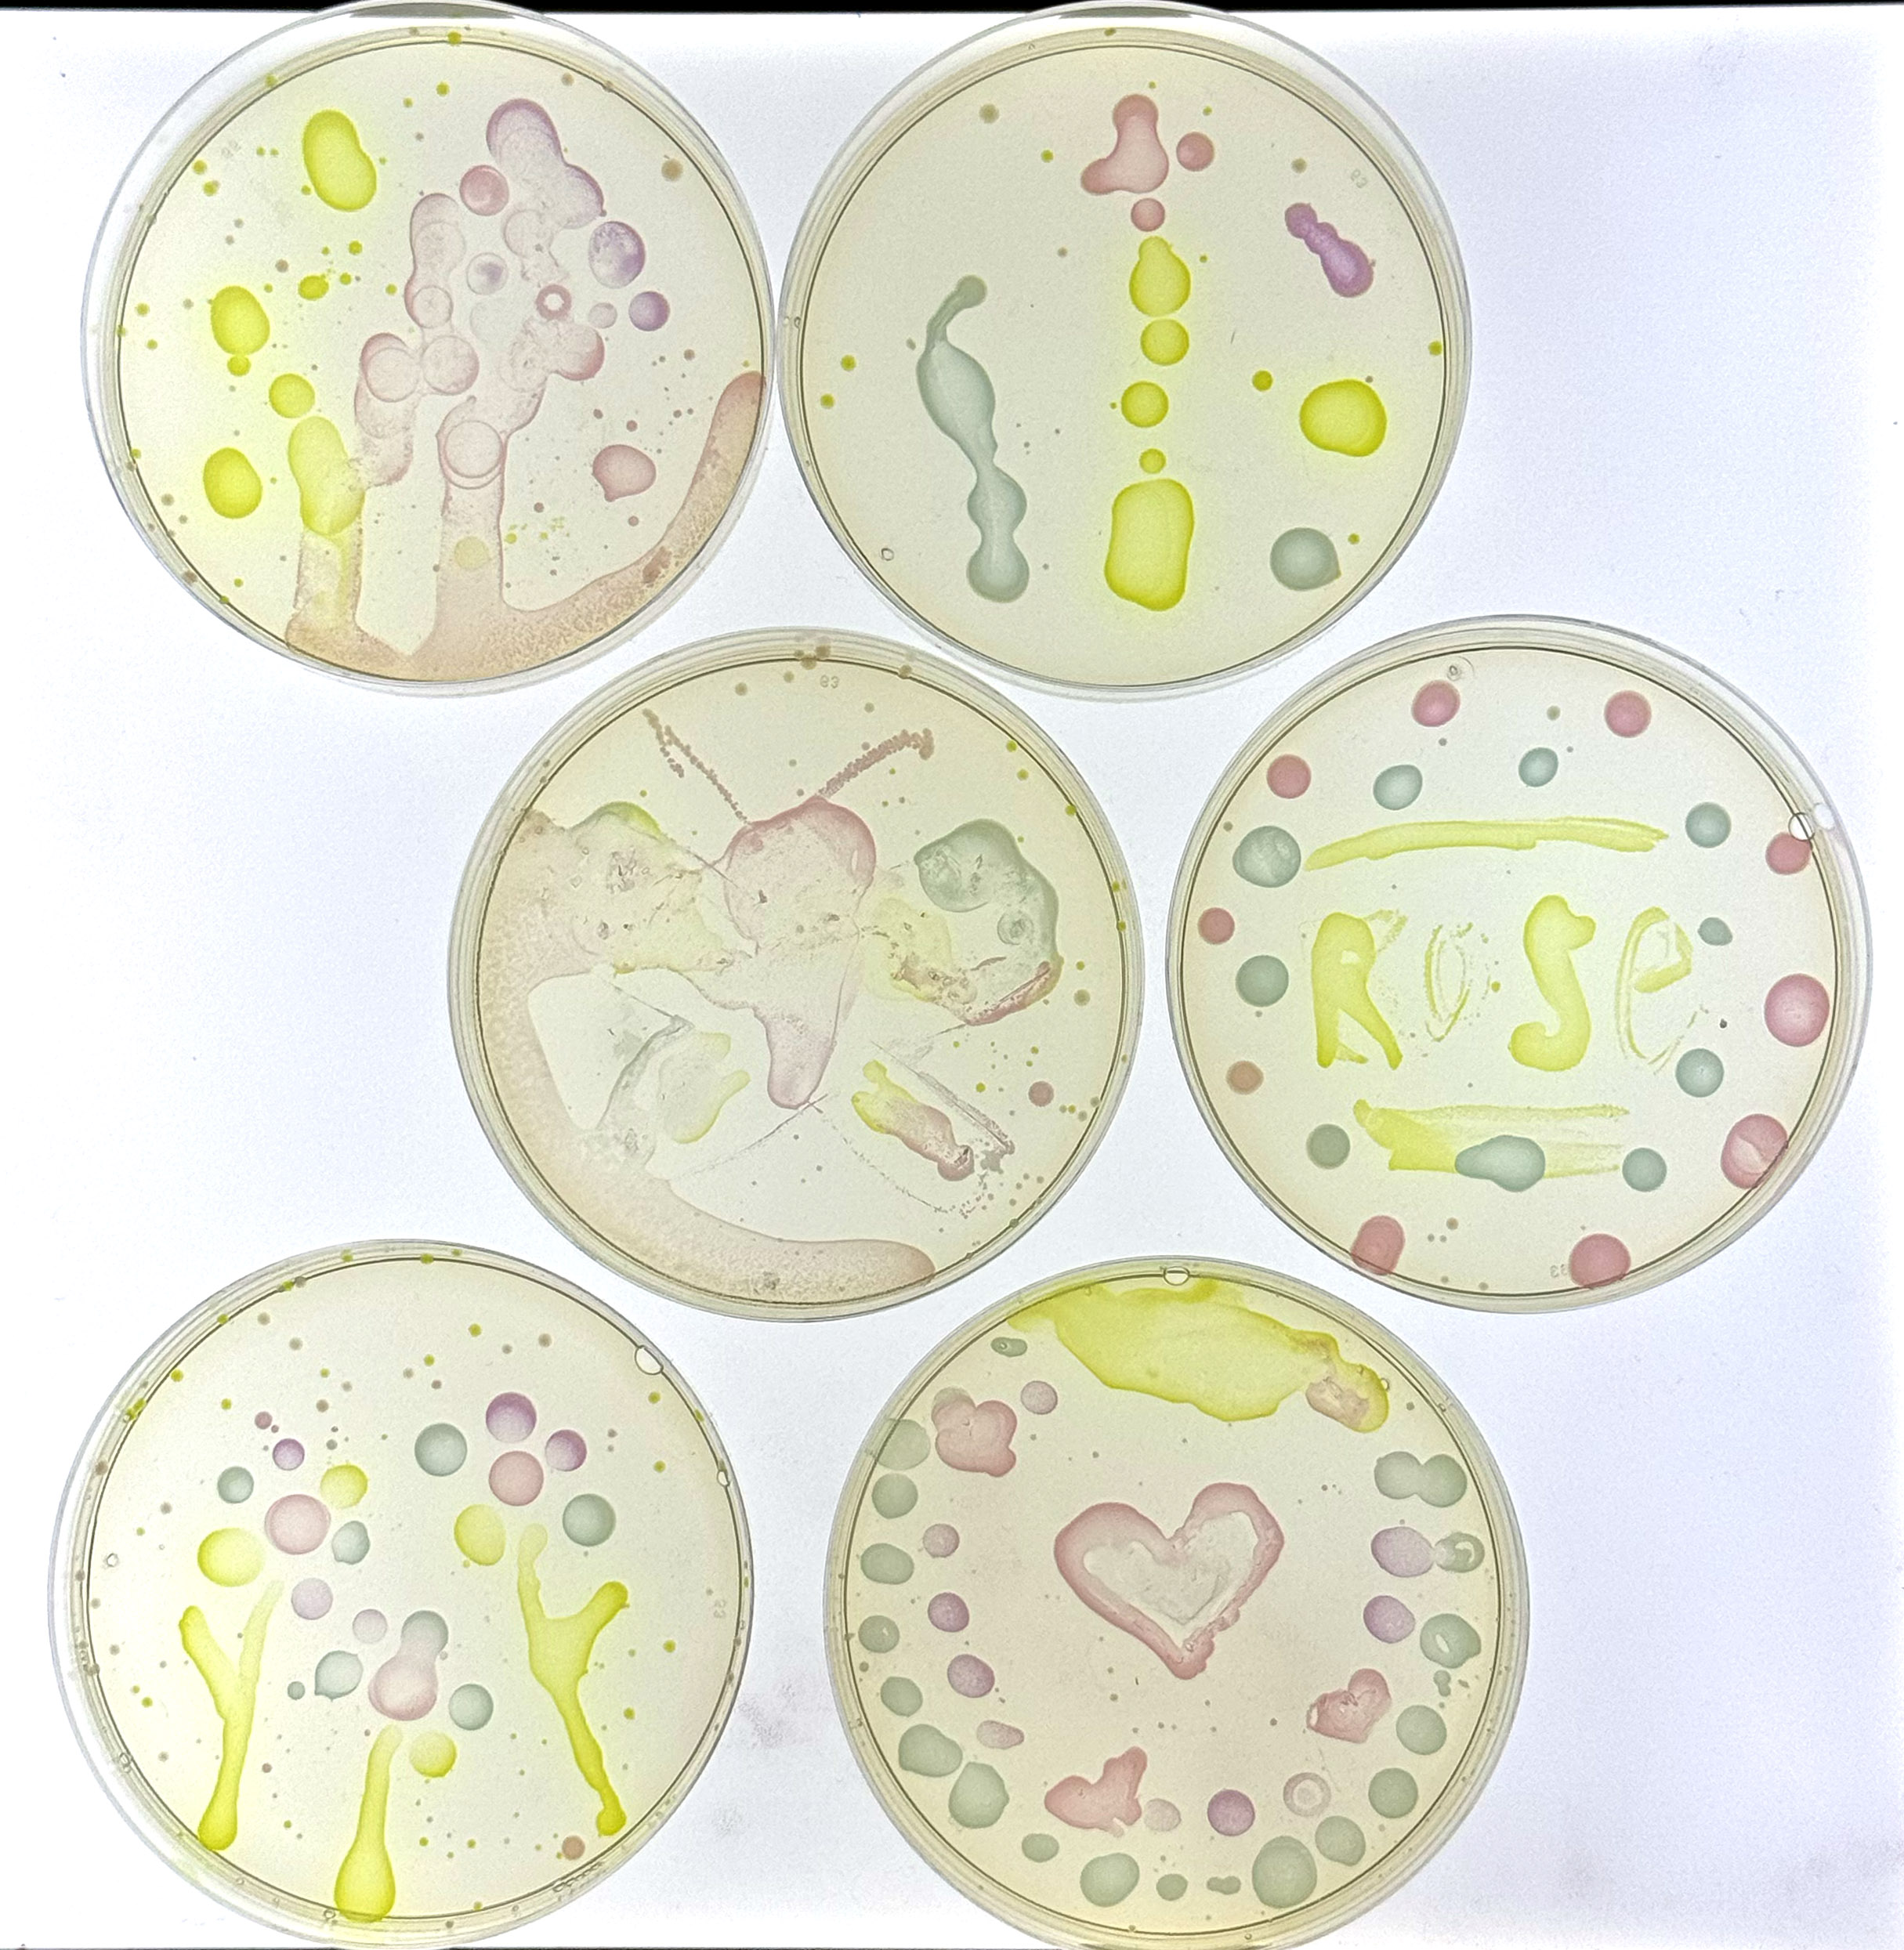
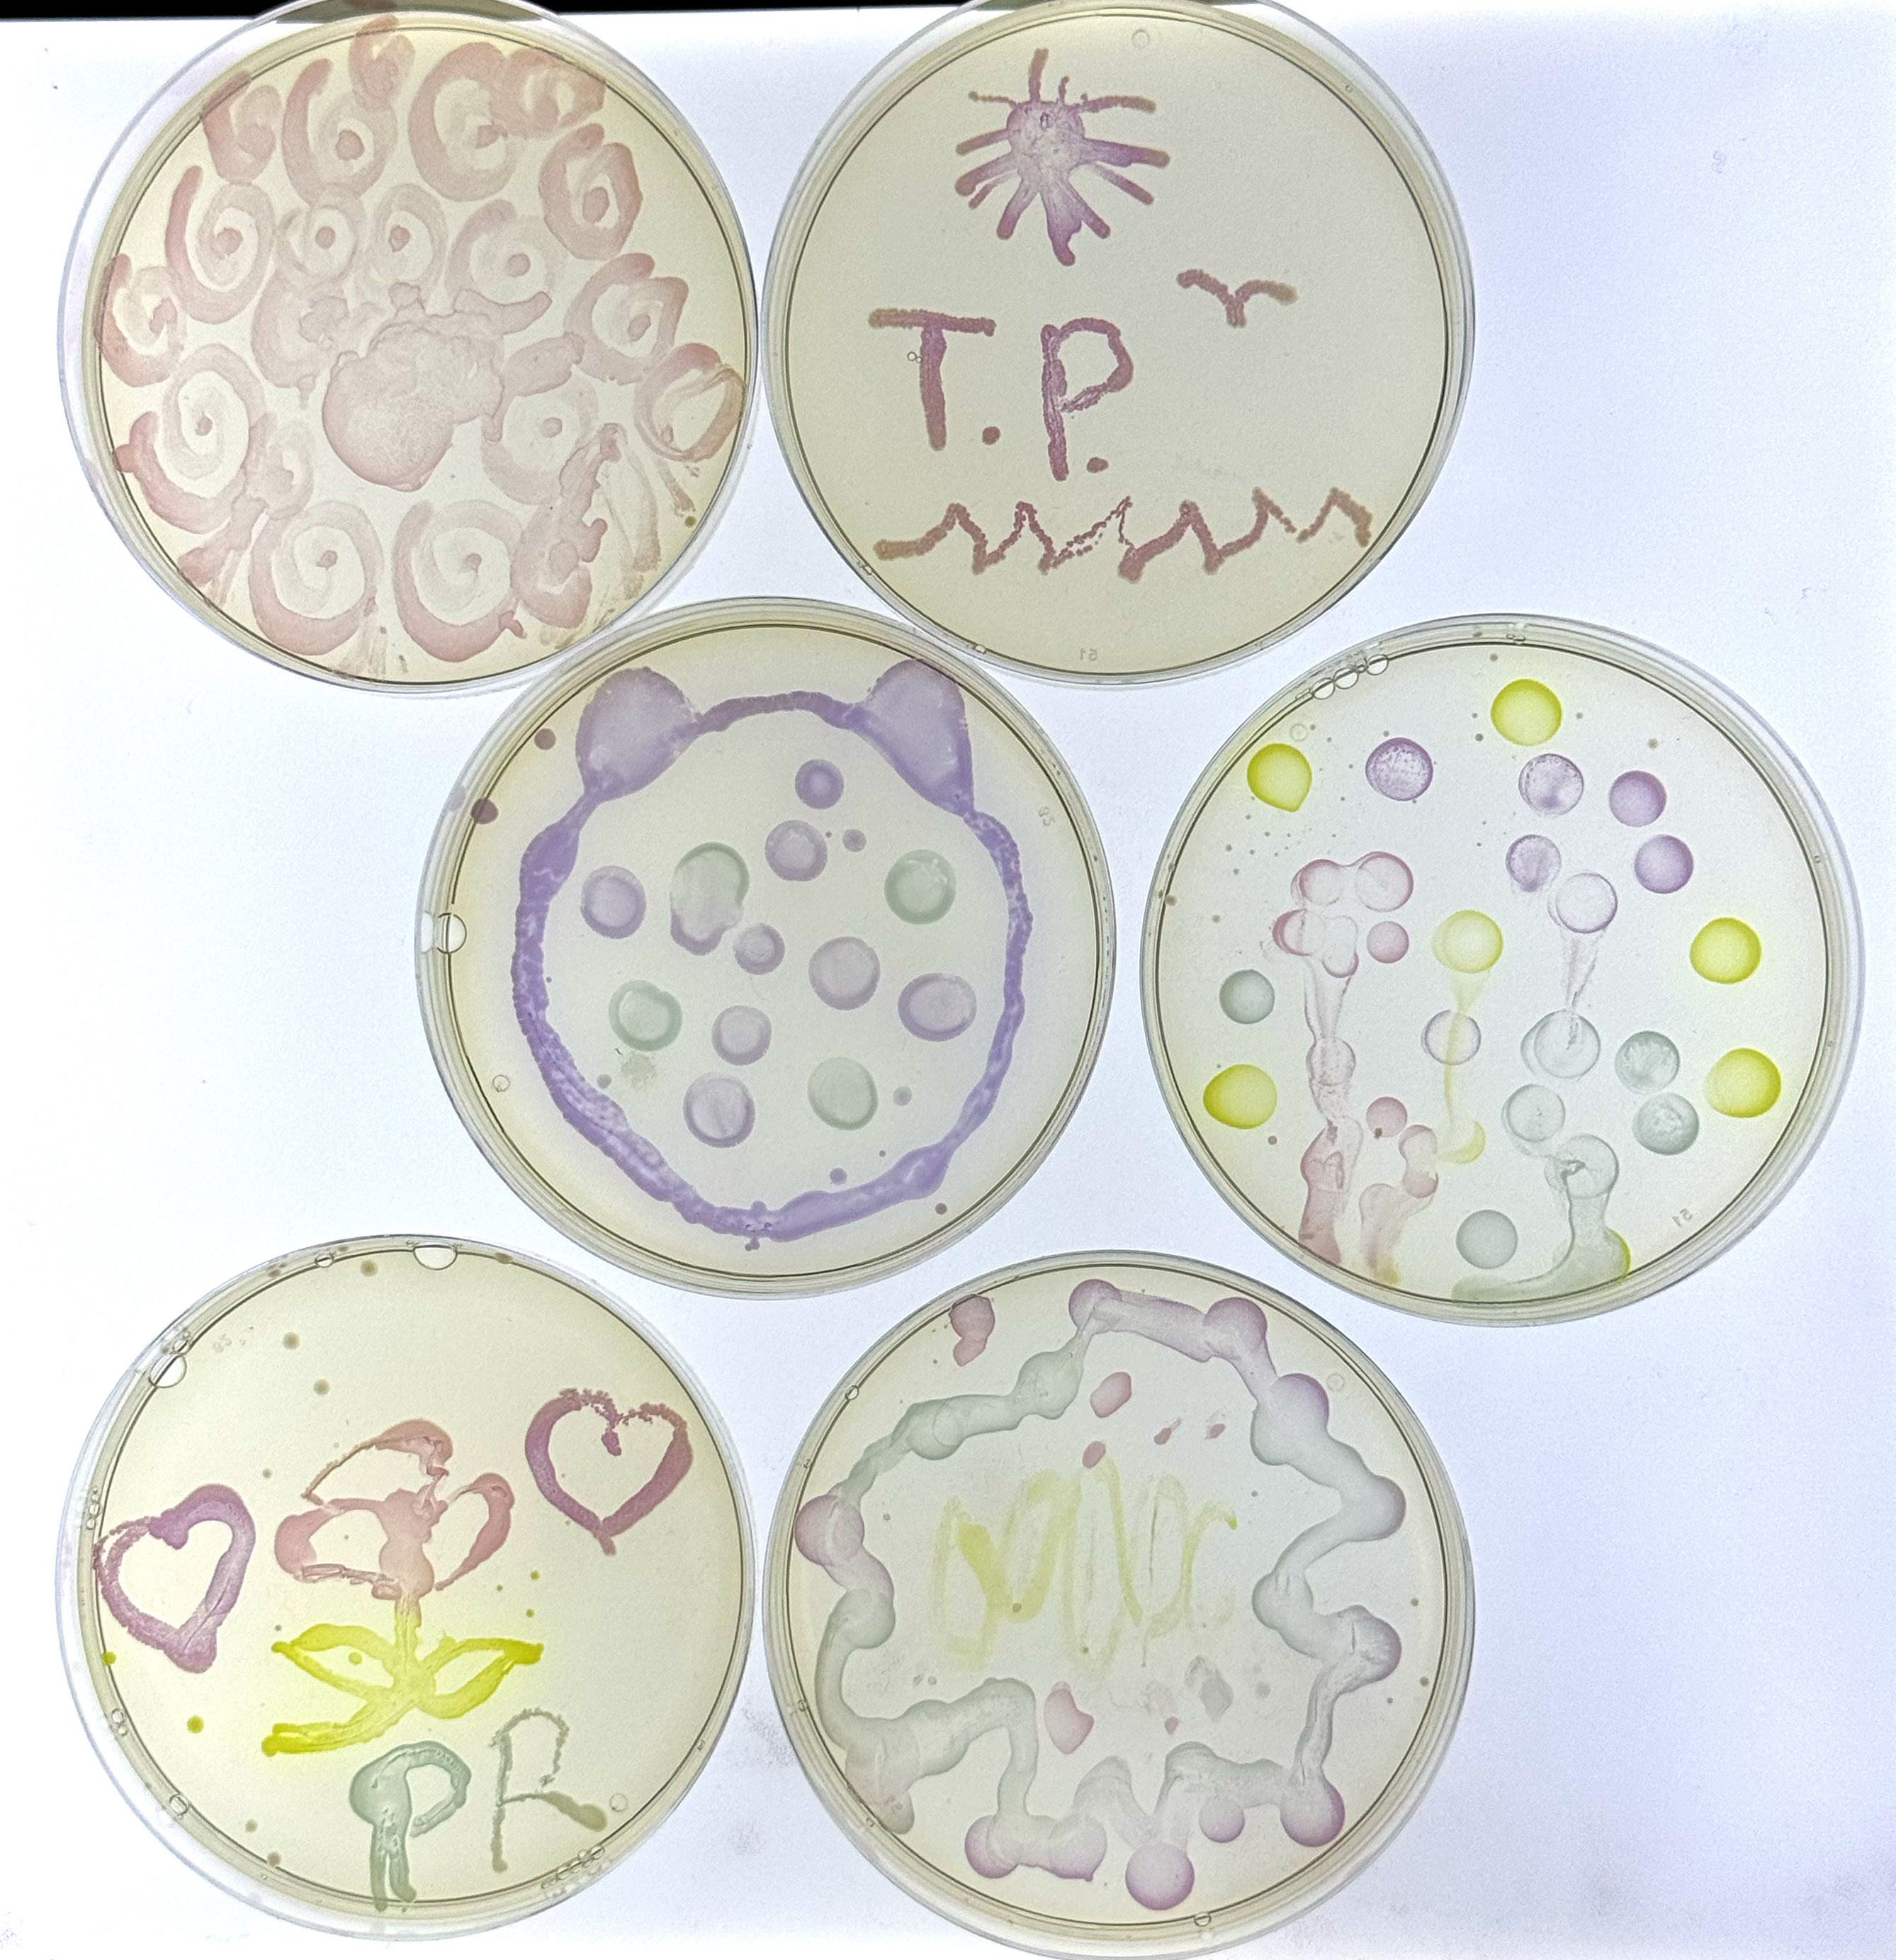

Last week the NSTA held their annual National Conference in Philadelphia, PA. This is one of our favorite conferences of the year since it gives us an opportunity to connect with teachers, administrators, and students! We wrote previously about the workshops that we were planning for the event, you can read about all SEVEN workshops here. Unsurprisingly, our teachers were amazing and the workshops all went perfectly. Hopefully our attendees enjoyed the experience as much as we did!
Today I wanted to post just one set of results that are too much fun not to share. One of our Friday workshops, Color Your Classroom: Engaging Students with Bacteria and Bio-Art, explored ways that instructors can use bacteria to bring some art into the classroom. Teachers learned some tips and tricks to get the best transformation results with their students. Next, they used transformed bacteria as a biological paint and unleashed their creativity on LB Agar plates! The bacteria express proteins that are blue, pink, purple, and green, producing a beautiful color as they grow. Check out our participant’s results below!

I’m always impressed by the creativity and artistic ability of our teachers! For those of you that were unable to attend the workshop, you can find out more information on the transformation and agar art in our blog post here. If you’re ready to try it in your classroom follow this link for more information. See you at a future conference!
